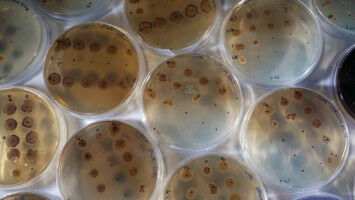
Melioidose: Neuer Ansatz gegen gef�hrliche Bakterieninfektion

news
Friedrich-Schiller-Universität Jena
Ergebnisse 141 - 160 von 306.
Gesundheit - Biowissenschaften - 21.09.2022

Einen neuartigen Therapieansatz zur Behandlung bösartiger Tumore des Lymphsystems hat ein Forschungsteam der Friedrich-Schiller-Universität Jena gemeinsam mit Forschenden des Universitätsklinikums Mainz, der Universität Regensburg und des IRCM in Montreal (Kanada) entdeckt. Wie das Team um PD Dr. Christian Kosan vom Institut für Biochemie und Biophysik zeigt, führt die Behandlung bestimmter B-Zell-Lymphome mit dem Enzym-Inhibitor ,,Marbostat 100" zu einem deutlich verlangsamten Wachstum der Tumorzellen.
Sozialwissenschaften - Psychologie - 20.09.2022

Ist die Frau zufrieden, dann ist auch mit der Beziehung alles in Ordnung. So lautet eine vermeintliche Regel, die in englischer Sprache gern mit der simplen Formel ,,Happy wife - happy life" pointiert zusammengefasst wird und mit der sich auch hierzulande ganze Comedyprogramme füllen lassen. Vereinzelte wissenschaftliche Befunde schienen in den 1980er Jahren durchaus nahezulegen, dass Frauen sensitiver für Beziehungsthemen seien und sich daraus Rückschlüsse auf die Zukunft einer Beziehung ziehen ließen.
Sozialwissenschaften - Psychologie - 20.09.2022

Ist die Frau zufrieden, dann ist auch mit der Beziehung alles in Ordnung. So lautet eine vermeintliche Regel, die in englischer Sprache gern mit der simplen Formel ,,Happy wife - happy life" pointiert zusammengefasst wird und mit der sich auch hierzulande ganze Comedyprogramme füllen lassen. Vereinzelte wissenschaftliche Befunde schienen in den 1980er Jahren durchaus nahezulegen, dass Frauen sensitiver für Beziehungsthemen seien und sich daraus Rückschlüsse auf die Zukunft einer Beziehung ziehen ließen.
Biowissenschaften - 09.09.2022

Farne gehören zu den Organismen mit dem umfangreichsten Erbgut, bis zu 720 Chromosomenpaare kann das Genom einer Farnpflanze aufweisen. Diese Überbordende Größe und Komplexität der meisten Farngenome hat es Forschenden bislang erschwert, grundlegende Aspekte der Farnbiologie und der Evolution der Landpflanzen durch genomgestützte Forschung zu klären.
Pharmakologie - Gesundheit - 08.09.2022

In der Target-Studie untersuchte ein Forschungsteam des Universitätsklinikums Jena (UKJ), ob die an der Konzentration im Blutplasma ausgerichtete Dosierung der Antibiotikatherapie bei Sepsis einen Vorteil bringt. Im Fachjournal "Intensive Care Medicine" stellt das Team die Ergebnisse einer kontrollierten multizentrischen Studie vor: In Bezug auf die Organfunktion konnten nur minimale, für Sterblichkeit und Heilungsrate geringe Verbesserungen erreicht werden, die jedoch nicht statistisch signifikant waren.
Astronomie & Weltraum - Geschichte & Archeologie - 05.09.2022

Mit fortschreitender Kernfusion im Innern eines Sterns ändern sich auch seine Helligkeit, Größe und Farbe. Die Astrophysik kann aus diesen Eigenschaften deshalb wichtige Informationen etwa zum Alter oder zur Masse eines Sterns herauslesen. Sterne mit deutlich mehr Masse als der Sonne sind blau-weiß oder rot - der Übergang zu Rot via Gelb und Orange geschieht für astronomische Verhältnisse dabei relativ rasch.
Physik - Materialwissenschaft - 01.09.2022

Rot wird nicht Grün und infrarotes Licht nicht plötzlich sichtbar, wenn man es durch einen Lichtleiter schickt. Denn Licht ändert seine Wellenlänge nicht einfach so. Es sei denn, der Mensch greift zu einem Trick. Den hat ein internationales Forschungsteam jetzt erstmals in optischen Fasern effektiv anwenden können.
Biowissenschaften - Paläontologie - 01.09.2022

Ein Team von Wissenschaftlern der Friedrich-Schiller-Universität Jena, der Universität Rennes in Frankreich, der Universität Gdansk in Polen sowie des Helmholtz-Zentrums Hereon in Geesthacht hat eine bisher unbekannte ausgestorbene Ameisenart entdeckt. Das Team hatte mit der Röntgenlichtquelle PETRA III am Deutschen Elektronen-Synchrotron (DESY) in Hamburg die entscheidenden fossilen Überreste von 13 individuellen Tieren untersucht und erkannt, dass sie keiner bekannten Art zugerechnet werden können.
Biowissenschaften - 16.08.2022

Die Fortpflanzung der Insektenordnung der Fächerflügler ist nichts für schwache Nerven: Um die Eizellen seiner Partnerin zu befruchten, verletzt das Fächerflügler-Männchen den ,,Hals" des Weibchens mit seinem hakenförmigen Penis und injiziert ihm die Samen direkt ins Körperinnere. Diese sogenannte traumatische Begattung ist für die Weibchen riskant.
Biowissenschaften - Gesundheit - 01.08.2022
Jenaer Forschende haben ein Enzym als neuen Ansatzpunkt gegen die gefährliche bakterielle Infektion Melioidose identifiziert. Das pathogene Bakterium "Burkholderia pseudomallei" nutzt es zum Bau einer molekularen Struktur, die eine entscheidende Rolle bei der Infektion spielt. Die Ergebnisse wurden in " Nature Chemistry" veröffentlicht.
Umwelt - Biowissenschaften - 30.06.2022

Mikroorganismen in Grundwasserleitern tief unter der Erdoberfläche produzieren ähnlich viel Biomasse wie solche in manchen Meeresbereichen. Zu diesem Ergebnis kommen Forschende unter Leitung der Friedrich-Schiller-Universität Jena und des Deutschen Zentrums für integrative Biodiversitätsforschung (iDiv).
Materialwissenschaft - Gesundheit - 17.06.2022

Werden mechanolumineszente Materialien von außen mechanisch belastet, dann emittieren sie sichtbares oder unsichtbares Licht. Eine solche Anregung kann zum Beispiel durch Knicken oder sanften Druck passieren, aber auch völlig berührungsfrei über Ultraschall. Auf diese Weise lässt sich der Effekt ferngesteuert auslösen und Licht an Orte bringen, die normalerweise eher im Dunkeln liegen - beispielsweise im menschlichen Körper.
Chemie - Biowissenschaften - 10.06.2022

Die chemischen Vorstufen unserer heutigen Biomoleküle könnten nicht nur in der Tiefsee an hydrothermalen Quellen entstanden sein, sondern auch in warmen Tümpeln an der Erdoberfläche. Die chemischen Reaktionen, die in dieser ,,Ursuppe" möglicherweise stattgefunden haben, hat ein internationales Team unter Leitung der Friedrich-Schiller-Universität Jena nun erstmalig im Experiment nachvollzogen.
Umwelt - Biowissenschaften - 01.06.2022

Ein internationales Forschungsteam hat jetzt die größte Datensammlung aus Kamerafallen über Tiere des Amazonas-Regenwaldes veröffentlicht. Die Sammlung umfasst derzeit über 120. Datensätze mit Zeitund Ortinformationen. Sie wird die Forschung über den Bestand, die Vielfalt und die Lebensraumbedingungen von Jaguaren, Tukanen, Harpyien und vielen anderen gefährdeten Regenwaldarten verbessern und zu deren Schutz beitragen.
Gesundheit - Pharmakologie - 27.04.2022

Mit einer aktuellen Metastudie konnten Forscherinnen am Universitätsklinikum Jena die Binsenweisheit, dass Lachen gesund ist, wissenschaftlich bestätigen. Die jetzt veröffentlichte Auswertung von 45 randomisiert-kontrollierten Studien, die die Wirkung von Lachtherapien in verschiedenen Patientengruppen testeten, ergab positive Effekte sowohl für physiologische Parameter als auch für die körperliche und seelische Gesundheit.
Gesundheit - Biowissenschaften - 21.04.2022

Ein Forschungsteam aus Jena und Berlin untersuchte den Einfluss verschiedener Reinigungsregimes auf die Menge, Vielfalt und Resistenzen der Bakterien, die auf den Oberflächen von Klinikzimmern zu finden sind. Bei der Anwendung eines probiotischen Reinigungsmittels kam es zu signifikanten Veränderungen der Bakterienflora der Krankenzimmer, insbesondere in den Waschbecken.
Gesundheit - Biowissenschaften - 19.04.2022

Anlässlich des Internationalen Tages des Versuchstiers am 24. April betonen die Forschenden an Universität und Klinikum Jena, dass sie sich ihrer großen Verantwortung bei der Durchführung von Tierversuchen bewusst sind. Mit zahlreichen Maßnahmen arbeiten sie darauf hin, die Zahl der Versuche und das Leid der Tiere auf das geringstmögliche Maß zu beschränken.
Gesundheit - Biowissenschaften - 13.04.2022

Mit einem von Jenaer Forschenden entwickelten Chip-basierten Infektionsmodell lässt sich die Schädigung von Lungengewebe durch die invasive Pilzinfektion Aspergillose live unter dem Mikroskop beobachten. Das Team entwickelte Algorithmen, um die Ausbreitung der Pilzhyphen sowie die Reaktion von Immunzellen zu verfolgen.
Biowissenschaften - 05.04.2022

Alles Leben auf der Erde verläuft im 24-Stunden-Takt: Von den kleinsten Bakterien bis zu den Menschen passen sich Organismen an den Wechsel von Tag und Nacht an. Dabei helfen ihnen die Wahrnehmung äußerer Faktoren, wie Licht und Temperatur, und deren Wechsel im Tag-Nacht-Verlauf. Zusätzlich werden Stoffwechselprozesse von einer inneren Uhr gesteuert.
Gesundheit - Pharmakologie - 18.03.2022

Ein Forschungsteam des Universitätsklinikums Jena untersuchte in einer kontrollierten multizentrischen Studie, ob die Reduktion von Entzündungsmarkern im Blut bei der chirurgischen Behandlung von bakteriellen Infektionen im Herzinneren einen Vorteil bringt. Die jetzt im Fachjournal Circulation vorgestellten Ergebnisse zeigen, dass das Verfahren keinen Einfluss auf den klinischen Erfolg der Behandlung hat, obwohl die Konzentration der Zytokine deutlich gesenkt werden kann.









